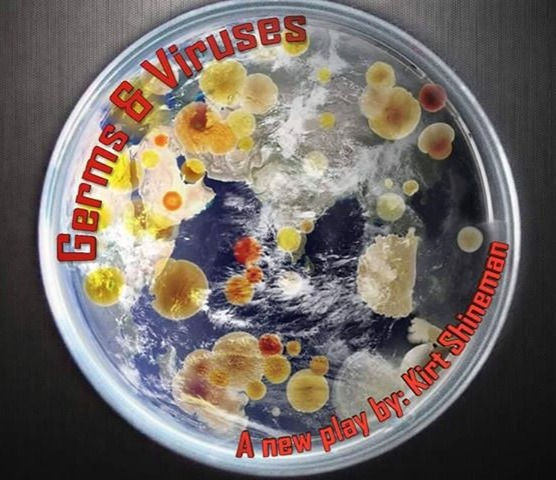

KIRT SHINEMAN: AÂ PLAYWRIGHT
I write about the emotions between the words.
Welcome to my official website. Here you will find information about myself, my career, latest projects, upcoming events, and learn so much more about my work. I appreciate your interest and involvement in my professional endeavors, and invite you to explore my site for more.









"Man is free at the moment he wishes to be"
Voltaire
KIRT SHINEMAN
PLAYWRIGHT RESUME
Dramaturgical Resume
Listen to a podcast of
Stripping Lord Byron
performed by Standby for Places
My New Radio Play:
Moments Before
posted April 2021

April 1, 2022

Announcements
​
Kissing Curse was a semi-finalist for Gerry Marshall Theater
​
B3 is producing Kissing Curse in the Fall 2022.
​
Cavemen Don't Do Crossfit
recorded and available at Theatre Artists Studio thestudiophx.org
Lost and Found was performed Veterans 10-Minute Play Festival 2020
​
Pluck the Day was a semi-finalist for B Street Theatre's 3rd Annual New Comedies Play Festival
​
A Life Assembled is now available to buy, to stage, and to read. Check out the book.
​
Allie Oop's Last Fantastic Day- available to buy, to stage and read at:
​
​
April 1, 2022
Recent & Upcoming Readings
​
Private Fire: NYC performance
​
Whitewashed a reading, May 11, 2021 at Theatre Artists Studio
The Mysterious Disappearance Produced at Theater Artists Studio in 2021 after Phoenix Theatre Company 2020 Festival of New American Theatre
​
​
​
Where They’re Going When They Leave?
a reading on Zoom
​

As of April 1, 2022